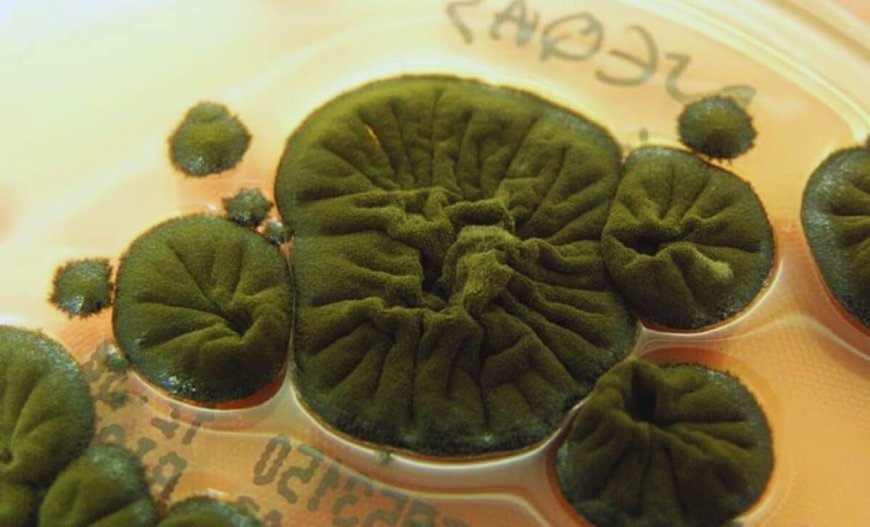
In The Ruins Of Chernobyl’s Reactor, Scientists Found A Fungus That Developed A Stunning Ability

In The Ruins Of Chernobyl’s Reactor, Scientists Found A Fungus That Developed A Stunning Ability
Deep inside the wreckage of Chernobyl’s Unit Four reactor, a black fungus is doing more than surviving. Cladosporium sphaerospermum appears to grow in the presence of ionizing radiation, prompting scientists to question whether it may be interacting with radiation in a way no complex organism was previously known to do.
Nearly 40 years after the 1986 disaster, the Chernobyl exclusion zone remains largely off-limits to humans. Radiation levels inside certain structures are still hazardous. Yet microbial life has steadily colonized these spaces, adapting to conditions once thought overwhelmingly hostile.
A Fungal Community Inside the Reactor Shelter
In the late 1990s, microbiologist Nelli Zhdanova of the Ukrainian National Academy of Sciences led a survey of the shelter surrounding the destroyed reactor. The team’s findings revealed 37 fungus species inhabiting the contaminated site.
Many of these organisms were dark in color, rich in the pigment melanin. Among them, Cladosporium sphaerospermum dominated the samples and displayed some of the highest levels of radioactive contamination. The prevalence of melanized fungi immediately drew attention, as melanin is known to absorb radiation and provide protection against cellular damage.

The sheer number of species found in such an extreme environment surprised researchers at the time. The presence of life was not unexpected; the diversity and resilience were.
Unexpected Growth in a Radioactive Zone
Ionizing radiation carries enough energy to remove electrons from atoms, a process that can break molecular bonds and damage DNA. In humans, this type of radiation increases cancer risk and can destroy living cells. In oncology, it is deliberately used to target tumors.
Yet experiments conducted by Ekaterina Dadachova and Arturo Casadevall at the Albert Einstein College of Medicine revealed a different response in Cladosporium sphaerospermum. As explained in their research, published in PLOS One, exposure to ionizing radiation did not suppress the fungus. Instead, the organism showed enhanced growth.

The researchers also reported that ionizing radiation altered the behavior of fungus melanin. In a 2008 paper, Dadachova and Casadevall proposed that melanin might enable a process similar to photosynthesis, which they termed radiosynthesis. In this hypothesis, radiation would be absorbed and converted into chemical energy, while melanin simultaneously shields the organism from harm.
A Hypothesis Still Awaiting Proof
The concept of radiosynthesis remains under investigation. Scientists have not demonstrated carbon fixation driven by ionizing radiation, nor identified a defined metabolic pathway confirming that radiation is converted into usable energy. According to engineer Nils Averesch of Stanford University and colleagues:
“Actual radiosynthesis, however, remains to be shown, let alone the reduction of carbon compounds into forms with higher energy content or fixation of inorganic carbon driven by ionizing radiation.”
Research has also shown that the response to radiation is not uniform among melanized fungus species.The black yeast Wangiella dermatitidis demonstrates enhanced growth under ionizing radiation, while Cladosporium cladosporioides increases melanin production under gamma or UV radiation without a corresponding boost in growth.
From Chernobyl’s damaged structures to orbit, this black fungus continues to challenge scientists. What remains unclear is how Cladosporium sphaerospermum interacts with ionizing radiation.
Enjoyed this article? Subscribe to our free newsletter for engaging stories, exclusive content, and the latest news.
What's Your Reaction?
 Like
0
Like
0
 Dislike
0
Dislike
0
 Love
0
Love
0
 Funny
0
Funny
0
 Angry
0
Angry
0
 Sad
0
Sad
0
 Wow
0
Wow
0






























 A black fungus feeds on radiation in Chernobyl.
A black fungus feeds on radiation in Chernobyl.















